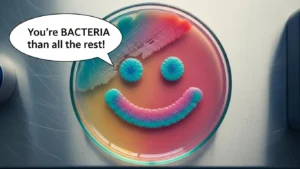
bacteria puns

290+ Deer Blind Dad Jokes That Will Keep You Laughing While You Wait
If you’ve ever sat in a deer blind long enough to question your life choices, congratulations—you’re perfectly primed for deer

If you’ve ever sat in a deer blind long enough to question your life choices, congratulations—you’re perfectly primed for deer

If you’re searching for humor that stands tall, ostrich puns are about to ruffle your feathers—in the best way possible.

If you’ve ever stared at a toaster and thought, “Wow, my breakfast is more put-together than I am,” this is

If you’ve ever stared at a lawn and thought, “Wow… that patch of grass has its life more together than

Food tastes better when it comes with a side of humor! Welcome to the ultimate collection of eating puns, where

If you’re volunteering for a laugh, you’ve landed in the right holler. This ultimate collection of Tennessee puns and Southern

Festivals aren’t just for lights, music, and food—they’re for laughs too! Welcome to the ultimate collection of festival puns, where
If your sense of humor tends to multiply faster than bacteria in a warm Petri dish, you’re in the right

If you’ve been searching for charity puns that give back in the form of laughter, congratulations — you just made

If you love esports puns almost as much as you love landing clutch plays, this blog is your loot drop

If you’re on the hunt for blackjack puns that hit harder than a perfect 21, you just shuffled into the

If you’re building a business in the City Beautiful, you might as well build your sense of humor too—because Orlando

If you’re looking for eye doctor jokes that are clean, clever, and totally family-friendly, you’re in the right place —

Ahoy there! Welcome aboard the ultimate treasure chest of pirate puns, where every joke is worth its weight in gold.

Looking for a shockingly bright way to light up your day? You’ve just plugged into the right outlet! Today we’re

If you love wholesome humor that rolls in smoothly, today’s your lucky day—because we’re diving into the world of fun,

Grab your baguette, tighten your beret, and prepare your best “bonjour,” because we’re diving into a full feast of French

If your sense of humor feels a little washed out, don’t worry—these washing machine puns are here to help you

If you think Teslas are just for silent drives and autopilot convenience, think again! 🚗⚡ Tesla jokes are the ultimate

If you love computer science jokes that compile perfectly in any mood, you’re in the right place. Whether you’re debugging

If you’re hunting for film jokes that hit harder than a plot twist in Act Three, you’ve landed at the

If you’re ready for humor that’s truly respiratory-level refreshing, you’ve inhaled the right blog! Today we’re diving deep into lung

If you’re ready to laugh like royalty, welcome to the kingdom of queen puns—where humor reigns supreme and every punchline

Why did the tie break up with the shirt? It couldn’t handle the knotty relationship! 👔 If you’re a fan

Why did the trash can become a comedian? Because it was full of garbage puns! 🗑️ From landfill laughs to

Ready to laugh harder than a compiler catching 97 errors from one missing semicolon? Welcome to the internet’s most complete

Why did the llama refuse to climb Machu Picchu? It didn’t want to be part of a “llama-ssive” joke! 🦙

Calculus doesn’t have to be all limits, derivatives, and integrals—it can also be a source of endless laughs! Whether you’re

Why did the coral blush? Because it saw the reef’s “tentacle” humor! 🐠 Coral puns bring the vibrant underwater world

If you’ve ever had your gallbladder act up at the worst possible moment, don’t worry—you’re in good company. Today we’re

Why did the dumpling go to comedy school? To learn how to roll out the best punchlines! 🥟 Dim sum

If your brain needs a quick dopamine boost, you’ve landed in the right cortex. This collection of neurology jokes and

Dust off your boots and tighten your saddle, because this roundup of cowboy jokes brings together the funniest ranch puns,

If you’ve been looking for optometry jokes that are crisp, clear, and full of vision-powered wit, you’ve come to the

Burrows aren’t just cozy homes for rabbits, moles, and other critters—they’re also a goldmine for clever humor! Burrow puns take

Why did the waffle go to therapy? Because it felt crumby! 🧇 If you love breakfast, brunch, or just punny

Why did the vampire read a book at the blood bank? Because he wanted to improve his literary circulation! 🩸

Why did the log sit next to the fireplace? Because it wanted to stay current! 🔥 Whether you’re sipping cocoa,

Ever read something so ridiculous it made you question your life choices? That’s brainrot in action! 🧠💀 From absurd internet

Y’all ever heard a joke so sweet it tastes like grandma’s sweet tea? 🍑 From front porch banter to witty